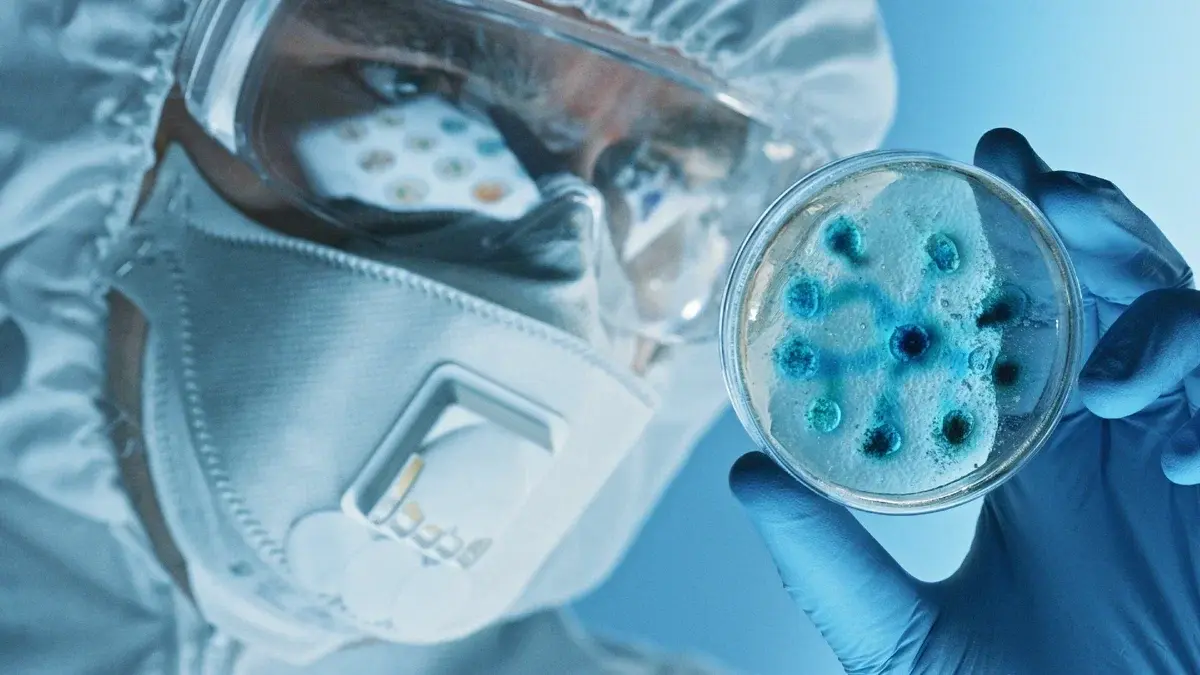

Продукты
E-mail
Телефон
Специалистам

Богатый внутренний мир: как микроорганизмы влияют на наше самочувствие
Долгое время микробы считались лишь вредными захватчиками, но современные исследования говорят об обратном: они играют ключевую роль в поддержании нашего здоровья, как физического, так и психического. Почему важно заботиться о микробиоме и как улучшить его состояние?
Второй геном
Внутри нас обитает целый мир – сложная экосистема, состоящая из бактерий, вирусов, грибков и других микроорганизмов, известных как микробиом. Состав микробиома для каждого человека уникален, как отпечаток пальца. Даже однояйцевые близнецы могут иметь совершенно разную кишечную флору и более того – на левой и правой руках одного человека состав микробиома может быть различным.
Всего в организме обитает от 500 до 1000 видов микроорганизмов. Их количество и качество варьируется в зависимости от возраста, генетических особенностей, гастрономических предпочтений, места проживания и социального статуса, а масса может достигать 3,5 кг.
Второй геном
Внутри нас обитает целый мир – сложная экосистема, состоящая из бактерий, вирусов, грибков и других микроорганизмов, известных как микробиом. Состав микробиома для каждого человека уникален, как отпечаток пальца. Даже однояйцевые близнецы могут иметь совершенно разную кишечную флору и более того – на левой и правой руках одного человека состав микробиома может быть различным.
Всего в организме обитает от 500 до 1000 видов микроорганизмов. Их количество и качество варьируется в зависимости от возраста, генетических особенностей, гастрономических предпочтений, места проживания и социального статуса, а масса может достигать 3,5 кг.

По разным данным, от 60 до 95% микроорганизмов находится в кишечнике – более 50 родов и более 500 видов бактерий, количество которых в ЖКТ человека на один порядок больше числа клеток человеческого организма. Но микробиом можно обнаружить практически во всех тканях организма: на коже, в ротовой полости, дыхательных путях, мочеполовой системе. Ученые называют микробиом вторым геномом человека и органом, равноценным сердцу, печени, легкому.
Функции микробиома не ограничиваются помощью пищеварению. Он взаимодействует с иммунной системой, обучая её распознавать полезные и вредные микроорганизмы, воздействует на обмен веществ и даже влияет на поведение и настроение. Поэтому дисбиоз, то есть нарушение баланса вредных и полезных бактерий в организме, чреват сбоем во многих системах и органах и может привести к развитию различных заболеваний, в том числе аллергии, астмы, сердечно-сосудистых и аутоиммунных заболеваний, ожирению и даже депрессии.
Чтобы улучшить состояние микробиома,важно помнить, что его состав зависит от того, в каких условиях мы живем, какой образ жизни ведём, что едим. Часто повлиять на микробиом можно просто изменив диету. Специалисты рекомендуют добавить в рацион кисломолочные продукты и клетчатку. А вот от сахара лучше отказаться: его избыток способствует росту патогенных бактерий и приводит к метаболическим нарушениям.
Функции микробиома не ограничиваются помощью пищеварению. Он взаимодействует с иммунной системой, обучая её распознавать полезные и вредные микроорганизмы, воздействует на обмен веществ и даже влияет на поведение и настроение. Поэтому дисбиоз, то есть нарушение баланса вредных и полезных бактерий в организме, чреват сбоем во многих системах и органах и может привести к развитию различных заболеваний, в том числе аллергии, астмы, сердечно-сосудистых и аутоиммунных заболеваний, ожирению и даже депрессии.
Чтобы улучшить состояние микробиома,важно помнить, что его состав зависит от того, в каких условиях мы живем, какой образ жизни ведём, что едим. Часто повлиять на микробиом можно просто изменив диету. Специалисты рекомендуют добавить в рацион кисломолочные продукты и клетчатку. А вот от сахара лучше отказаться: его избыток способствует росту патогенных бактерий и приводит к метаболическим нарушениям.

Для микрофлоры полезны кратковременные ограничения в пище: посты и разгрузочные дни. Главное, не переусердствовать, так как длительное голодание может привести, наоборот, к дисбиозу.
Важно контролировать прием лекарств. Ингибиторы протонной помпы, антидепрессанты, слабительные и другие медикаменты не лучшим образом влияют на наш «внутренний мир». Однако настоящие «токсики» для микрофлоры – антибиотики, которые, подобно химическому оружию, разрушают её. Восстановление после курса антибактериальной терапии может занять более полугода.
Улучшить микробиом можно и с помощью физических нагрузок. Согласно некоторым исследованиям, микрофлора спортсменов разнообразнее, да и качество – лучше, чем у тех, кто ведёт малоактивный образ жизни.
Применение пробиотиков – ещё один эффективный способ восстановления микробиома и поддержания его здоровья.
Невидимые помощники организма
Пробиотики (от греч. pro – «для», bios – «жизнь») – «это живые микроорганизмы, которые при введении в адекватном количестве оказывают положительный эффект на здоровье организма-хозяина» . Проще говоря, это «хорошие», полезные бактерии.
Важно контролировать прием лекарств. Ингибиторы протонной помпы, антидепрессанты, слабительные и другие медикаменты не лучшим образом влияют на наш «внутренний мир». Однако настоящие «токсики» для микрофлоры – антибиотики, которые, подобно химическому оружию, разрушают её. Восстановление после курса антибактериальной терапии может занять более полугода.
Улучшить микробиом можно и с помощью физических нагрузок. Согласно некоторым исследованиям, микрофлора спортсменов разнообразнее, да и качество – лучше, чем у тех, кто ведёт малоактивный образ жизни.
Применение пробиотиков – ещё один эффективный способ восстановления микробиома и поддержания его здоровья.
Невидимые помощники организма
Пробиотики (от греч. pro – «для», bios – «жизнь») – «это живые микроорганизмы, которые при введении в адекватном количестве оказывают положительный эффект на здоровье организма-хозяина» . Проще говоря, это «хорошие», полезные бактерии.
Какое влияние они оказывают на организм?
Но и хорошие микроорганизмы различаются между собой. Например, лактобактерии – это род кисломолочных бактерий, насчитывающий около130 видов, в том числе Lactobacillus plantarum (L.plantarum). Различные виды бактерий по-разному воздействуют на организм. Более того, даже разные штаммы одного вида пробиотиков могут иметь разные свойства:
Таргетный пробиотический штамм может помочь в решении конкретной задачи. Узнайте подробнее в штаммотеке «Бифистим®».
- Конкурируют с вредными бактериями за место в кишечнике, не давая им размножаться и вызывать проблемы.
- Улучшают барьерную функцию кишечника, предотвращая проникновение в кровь токсинов и аллергенов.
- Помогают расщеплять пищу, усваивать питательные вещества и бороться с такими проблемами, как вздутие живота, запоры или диарея.
- Так как большая часть иммунной системы находится в кишечнике, пробиотики помогают укрепить иммунитет.
Но и хорошие микроорганизмы различаются между собой. Например, лактобактерии – это род кисломолочных бактерий, насчитывающий около130 видов, в том числе Lactobacillus plantarum (L.plantarum). Различные виды бактерий по-разному воздействуют на организм. Более того, даже разные штаммы одного вида пробиотиков могут иметь разные свойства:
- L. Plantarum CECT 7481 подходит для сохранения баланса микрофлоры полости рта, т.к. он устойчив к воздействию слюны и способен подавлять патогенные микроорганизмы полости рта;
- L. Plantarum DR7 воздействует на ментальное здоровье, так как влияет на синтез нейротрансмиттеров дофамина и серотонина и подавляет выработку гормона стресса – кортизола;
- L. Plantarum CBT LP3 может облегчить симптомы колита т.к. оказывает противовоспалительное действие и восстанавливает защитные свойства кишечника;
- L. Plantarum CECT 7315 и CECT 7316 благоприятно влияют на иммунитет, т.к. увеличивают синтез противовоспалительного цитокина IL-10 – важнейшего регулятора нашего иммунитета.
Таргетный пробиотический штамм может помочь в решении конкретной задачи. Узнайте подробнее в штаммотеке «Бифистим®».
Таргетные пробиотики «Бифистим®» содержат комбинации штаммов, которые оказывают положительное влияние на разные системы. Линейка «Бифистим®» представлена пятью продуктами, каждый из которых нацелен на помощь организму в разных ситуациях.
Микробиом – это сложная, динамичная экосистема, которая играет важную роль в нашем организме, влияя на работу практически всех органов. Сбалансированное питание, богатое клетчаткой, употребление ферментированных продуктов, ограничение антибиотиков и стресса – простые способы сохранить «внутренний баланс». Но если он всё-таки нарушен, восстановить его помогут пробиотики. Обладая таргетным действием, грамотно подобранный штамм или комбинация штаммов, может решить различные проблемы со здоровьем и значительно улучшить самочувствие.
Источники:
1. Калмыкова А. Нас много. Микробиота современного человека // Наука из первых рук. №1(99), 2024. Режим доступа: https://elementy.ru/nauchno-populyarnaya_biblioteka/437231/Nas_mnogo_Mikrobiota_sovremennogo_cheloveka
2. Кайбышева В.О., Жарова М.Е., Филимендикова К.Ю., Никонов Е.Л. Микробиом человека: возрастные изменения и функции. Доказательная гастроэнтерология. 2020;9(2):42–55.
3. Кайбышева В.О., Никонов Е.Л. Пробиотики с позиции доказательной медицины. Доказательная гастроэнтерология. 2019;8(3):45‑54. DOI: 10.17116/dokgastro2019803145
4. Кузнецова Э.Э., Горохова В.Г., Богородская С.Л. Микробиота кишечника. Роль в развитии различных патологий. Клиническая лабораторная диагностика. 2016; 61(10): 723-726. DOI:10.18821/0869-2084-2016-61-10-723-726
5. Кузнецова М.С., Петрова И.В.Современные методы изучения микробиома человека и их применения в медицине // Наука и мировоззрение. https://naukamirowozreniya.ru/public/202503/application/1743096795620157116/sovremennye-metody-v-izuchenii-mikrobioma-cheloveka-i-ih-primeneniya-v-medicine.pdf
6. Микробиом, микробиота. Что нового? // Медицинский Совет. 2016;(16):92-97. https://doi.org/10.21518/2079-701X-2016-16-92-97
7. Харитонова Л. А., Григорьев К. И., Борзакова С. Н. Микробиота человека: как новая научная парадигма меняет медицинскую практику. Экспериментальная и клиническая гастроэнтерология. 2019;161(1): 55–63. DOI: 10.31146/1682-8658-ecg-161-1-55-63
8. Ashaolu TJ. Immune boosting functional foods and their mechanisms: A critical evaluation of probiotics and prebiotics. Biomed Pharmacother. 2020 Oct;130:110625.
9. Hill C, Guarner F, Reid G, Gibson GR, Merenstein DJ, Pot B. Expert consensus document: The International Scientific Association for Probiotics and Prebiotics consensus statement on the scope and appropriate use of the term probiotic. Nature Reviews Gastroenterology and Hepatology. 2014;11(8):506-514. https://doi.org/10.1038/nrgastro.2014.66
- Иммунобиотик с витаминно-минеральным комплексом «Бифистим® Иммуно» благодаря комбинации штаммов L. plantarum CECT 7316 и 7315 и витаминно-минеральному комплексу, укрепит защитные системы организма и будет полезен в сезон простуд, при частых ОРВИ, при астении после болезни, а также после вакцинации.
- Пробиотик «Бифистим® Бэби», содержащий штаммы P. pentosaceus CECT 8330 и B. longum CECT 7894, предназначен для детей с первых дней жизни. Он облегчит формирование собственного микробиома кишечника, укрепит иммунную систему малыша и поможет ему пережить младенческие колики.
- Дентабиотик «Бифистим® Дента» спасёт от неприятного запаха изо рта, снизит кровоточивость дёсен, укрепит иммунитет слизистой ротовой полости. Всё это – результат работы штаммов L. brevis CECT 7480 и L. plantarum CECT 7481.
- Психобиотик «Бифистим® Антистресс» основной компонент которого – штамм Lactobacillus plantarum DR7, поддержит в период психоэмоциональных и умственных нагрузок: уменьшит тревогу и раздражительность, снизит влияние стресса на организм, улучшит когнитивные функции.
- Синбиотик «Бифистим® Форте» поможет решить проблемы с кишечником и наладить его работу при несбалансированном питании и изменении рациона, после кишечных инфекций, во время приёма антибиотиков и при проблемах с пищеварением. Спасает желудочно-кишечный тракт целая команда штаммов: Bifidobacterium Bifidum CBT BF3, Lactobacillus casei cbt LC5, Lactobacillus Plantarum CBT LP3, Bifidobacterium Longum CBT BG7, Lactobacillus Acidophilus LA1.
Микробиом – это сложная, динамичная экосистема, которая играет важную роль в нашем организме, влияя на работу практически всех органов. Сбалансированное питание, богатое клетчаткой, употребление ферментированных продуктов, ограничение антибиотиков и стресса – простые способы сохранить «внутренний баланс». Но если он всё-таки нарушен, восстановить его помогут пробиотики. Обладая таргетным действием, грамотно подобранный штамм или комбинация штаммов, может решить различные проблемы со здоровьем и значительно улучшить самочувствие.
Источники:
1. Калмыкова А. Нас много. Микробиота современного человека // Наука из первых рук. №1(99), 2024. Режим доступа: https://elementy.ru/nauchno-populyarnaya_biblioteka/437231/Nas_mnogo_Mikrobiota_sovremennogo_cheloveka
2. Кайбышева В.О., Жарова М.Е., Филимендикова К.Ю., Никонов Е.Л. Микробиом человека: возрастные изменения и функции. Доказательная гастроэнтерология. 2020;9(2):42–55.
3. Кайбышева В.О., Никонов Е.Л. Пробиотики с позиции доказательной медицины. Доказательная гастроэнтерология. 2019;8(3):45‑54. DOI: 10.17116/dokgastro2019803145
4. Кузнецова Э.Э., Горохова В.Г., Богородская С.Л. Микробиота кишечника. Роль в развитии различных патологий. Клиническая лабораторная диагностика. 2016; 61(10): 723-726. DOI:10.18821/0869-2084-2016-61-10-723-726
5. Кузнецова М.С., Петрова И.В.Современные методы изучения микробиома человека и их применения в медицине // Наука и мировоззрение. https://naukamirowozreniya.ru/public/202503/application/1743096795620157116/sovremennye-metody-v-izuchenii-mikrobioma-cheloveka-i-ih-primeneniya-v-medicine.pdf
6. Микробиом, микробиота. Что нового? // Медицинский Совет. 2016;(16):92-97. https://doi.org/10.21518/2079-701X-2016-16-92-97
7. Харитонова Л. А., Григорьев К. И., Борзакова С. Н. Микробиота человека: как новая научная парадигма меняет медицинскую практику. Экспериментальная и клиническая гастроэнтерология. 2019;161(1): 55–63. DOI: 10.31146/1682-8658-ecg-161-1-55-63
8. Ashaolu TJ. Immune boosting functional foods and their mechanisms: A critical evaluation of probiotics and prebiotics. Biomed Pharmacother. 2020 Oct;130:110625.
9. Hill C, Guarner F, Reid G, Gibson GR, Merenstein DJ, Pot B. Expert consensus document: The International Scientific Association for Probiotics and Prebiotics consensus statement on the scope and appropriate use of the term probiotic. Nature Reviews Gastroenterology and Hepatology. 2014;11(8):506-514. https://doi.org/10.1038/nrgastro.2014.66